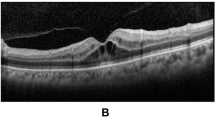

Abstract
Purpose
To correlate the response of topical dorzolamide (Trusopt; Merck) in patients with X-linked retinoschisis (XLRS) with genotype.
Methods
We carried out a retrospective evaluation of four patients (seven eyes) with XLRS, treated with topical dorzolamide. The change in best-corrected visual acuity (VA) and central macular thickness (CMT; central 1 mm subfield thickness) from optical coherence tomography (OCT) was analysed over the follow-up period, using Student's t-test. Each patient also had genetic analysis for mutations in the retinoschisisgene (RS1).
Results
The mean age at the start of treatment was 14.7±11 years, and mean follow-up duration was 21.7±7.7 months. Mean CMT at the final follow-up was significantly better than at baseline (291±123 vs352±119 μm, P=0.007); however, mean VA was worse (0.38±0.25 vs0.31±0.24 logMAR score, P=0.041). All four patients had a mutation in the RS1gene; there was no apparent association between the type of mutation and the response to topical dorzolamide.
Conclusion
Topical dorzolamide may have some effect in reducing central macular thickness in patients with XLRS, but this does not necessarily correlate with improvement in VA. In our case series, genotypic information did not predict the response to this treatment.
Similar content being viewed by others
Log in or create a free account to read this content
Gain free access to this article, as well as selected content from this journal and more on nature.com
or
Accession codes
References
de la Chapelle A, Alitalo T, Forsius H . X-linked juvenile retinoschisis. In: Wright A, Jay B (eds). Molecular Genetics of Inherited Eye Disorders, 1st edn., Harwood Academic Publishers: Switzerland, 1994, pp 339–357.
Sikkink SK, Biswas S, Parry NR, Stanga PE, Trump D . X-linked retinoschisis: an update. J Med Genet 2007; 44: 225–232.
Iannaccone A, Fung KH, Eyestone ME, Stone EM . Treatment of adult-onset acute macular retinoschisis in enhanced s-cone syndrome with oral acetazolamide. Am J Ophthalmol 2009; 147: 307–312.
Forsius H, Krause U, Helve J, Vuopala V, Mustonen E, Vainio-Mattila B et al. Visual acuity in 183 cases of X-chromosomal retinoschisis. Can J Ophthalmol 1973; 8: 385–393.
Grayson C, Reid SN, Ellis JA, Rutherford A, Sowden JC, Yates JR et al. Retinoschisin, the X-linked retinoschisis protein, is a secreted photoreceptor protein, and is expressed and released by Weri-Rb1 cells. Hum Mol Genet 2000; 9: 1873–1879.
Zeng Y, Takada Y, Kjellstrom S, Hiriyanna K, Tanikawa A, Wawrousek E et al. RS-1 gene delivery to an adult Rs1h knockout mouse model restores ERG b-wave with reversal of the electronegative waveform of X-linked retinoschisis. Invest Ophthalmol Vis Sci 2004; 45: 3279–3285.
Ewing CC, Ives EJ . Juvenile hereditary retinoschisis. Trans Ophthalmol Soc UK 1970; 89: 29–39.
Ando A, Takahashi K, Sho K, Matsushima M, Okamura A, Uyama M . Histopathological findings of X-linked retinoschisis with neovascular glaucoma. Graefes Arch Clin Exp Ophthalmol 2000; 238: 1–7.
Sarin LK, Green WR, Dailey EG . Juvenile retinoschisis. Congenital vascular veils and hereditary retinoschisis. Am J Ophthalmol 1964; 57: 793–796.
Sauer CG, Gehrig A, Warneke-Wittstock R, Marquardt A, Ewing CC, Gibson A et al. Positional cloning of the gene associated with X-linked juvenile retinoschisis. Nat Genet 1997; 17: 164–170.
Wu WW, Molday RS . Defective discoidin domain structure, subunit assembly, and endoplasmic reticulum processing of retinoschisin are primary mechanisms responsible for X-linked retinoschisis. J Biol Chem 2003; 278: 28139–28146.
Wu WW, Wong JP, Kast J, Molday RS . RS1, a discoidin domain-containing retinal cell adhesion protein associated with X-linked retinoschisis, exists as a novel disulfide-linked octamer. J Biol Chem 2005; 280: 10721–10730.
Manschot WA . Pathology of hereditary juvenile retinoschisis. Arch Ophthalmol 1972; 88: 131–138.
Yanoff M, Kertesz RE, Zimmerman LE . Histopathology of juvenile retinoschisis. Arch Ophthalmol 1968; 79: 49–53.
Brucker AJ, Spaide RF, Gross N, Klancnik J, Noble K . Optical coherence tomography of X-linked retinoschisis. Retina 2004; 24: 151–152.
Ozdemir H, Karacorlu S, Karacorlu M . Optical coherence tomography findings in familial foveal retinoschisis. Am J Ophthalmol 2004; 137: 179–181.
Wang T, Waters CT, Rothman AM, Jakins TJ, Romisch K, Trump D . Intracellular retention of mutant retinoschisin is the pathological mechanism underlying X-linked retinoschisis. Hum Mol Genet 2002; 11: 3097–3105.
Jablonski MM, Dalke C, Wang X, Lu L, Manly KF, Pretsch W et al. An ENU-induced mutation in Rs1h causes disruption of retinal structure and function. Mol Vis 2005; 11: 569–581.
Weber BH, Schrewe H, Molday LL, Gehrig A, White KL, Seeliger MW et al. Inactivation of the murine X-linked juvenile retinoschisis gene, Rs1h, suggests a role of retinoschisin in retinal cell layer organization and synaptic structure. Proc Natl Acad Sci USA 2002; 99: 6222–6227.
Deutman A, Hoyng C, van Lith-Verhoeven J . Macular dystrophies. In: Ryan S, Hinton D, Schachat A (eds). Retina, 4th edn. Elsevier/Mosby: Philadelphia, PA, 2006, pp 1165.
Apushkin MA, Fishman GA . Use of dorzolamide for patients with X-linked retinoschisis. Retina 2006; 26: 741–745.
Ghajarnia M, Gorin MB . Acetazolamide in the treatment of X-linked retinoschisis maculopathy. Arch Ophthalmol 2007; 125: 571–573.
Walia S, Fishman GA, Molday RS, Dyka FM, Kumar NM, Ehlinger MA et al. Relation of response to treatment with dorzolamide in X-linked retinoschisis to the mechanism of functional loss in retinoschisin. Am J Ophthalmol 2009; 147: 111–115.
Genead MA, Fishman GA, Walia S . Efficacy of sustained topical dorzolamide therapy for cystic macular lesions in patients with X-linked retinoschisis. Arch Ophthalmol 2010; 128: 190–197.
Leung CK, Cheung CY, Weinreb RN, Lee G, Lin D, Pang CP et al. Comparison of macular thickness measurements between time domain and spectral domain optical coherence tomography. Invest Ophthalmol Vis Sci 2008; 49: 4893–4897.
Grover S, Fishman GA, Gilbert LD, Anderson RJ . Reproducibility of visual acuity measurements in patients with retinitis pigmentosa. Retina 1997; 17: 33–37.
George ND, Yates JR, Bradshaw K, Moore AT . Infantile presentation of X linked retinoschisis. Br J Ophthalmol 1995; 79: 653–657.
Joint Formulary Committee. British National Formulary, 59 ed. British Medical Association and Royal Pharmaceutical Society of Great Britain: London, 2010. www.bnf.org/bnf. BNF 56.
Silver LH . Ocular comfort of brinzolamide 1.0% ophthalmic suspension compared with dorzolamide 2.0% ophthalmic solution: results from two multicenter comfort studies. Brinzolamide Comfort Study Group. Surv Ophthalmol 2000; 44 (Suppl 2): S141–S145.
Stewart WC, Day DG, Stewart JA, Holmes KT, Jenkins JN . Short-term ocular tolerability of dorzolamide 2% and brinzolamide 1% vs placebo in primary open-angle glaucoma and ocular hypertension subjects. Eye 2004; 18: 905–910.
Marmor MF, Abdul-Rahim AS, Cohen DS . The effect of metabolic inhibitors on retinal adhesion and subretinal fluid resorption. Invest Ophthalmol Vis Sci 1980; 19: 893–903.
Marmor MF, Maack T . Enhancement of retinal adhesion and subretinal fluid resorption by acetazolamide. Invest Ophthalmol Vis Sci 1982; 23: 121–124.
Wolfensberger TJ, Chiang RK, Takeuchi A, Marmor MF . Inhibition of membrane-bound carbonic anhydrase enhances subretinal fluid absorption and retinal adhesiveness. Graefes Arch Clin Exp Ophthalmol 2000; 238: 76–80.
Kita M, Marmor MF . Effects on retinal adhesive force in vivo of metabolically active agents in the subretinal space. Invest Ophthalmol Vis Sci 1992; 33: 1883–1887.
Wang T, Zhou A, Waters CT, O’Connor E, Read RJ, Trump D . Molecular pathology of X linked retinoschisis: mutations interfere with retinoschisin secretion and oligomerisation. Br J Ophthalmol 2006; 90: 81–86.
Acknowledgements
We acknowledge the East Anglian Molecular Genetics Laboratory at Addenbrooke's Hospital, Cambridge, UK, for performing molecular genetic testing and for providing genotype data for the patients. We also thank Frimley Park Hospital NHS Trust, the TFC Frost Charitable Trust, and the Gift of Sight Appeal for providing funding.
Author information
Authors and Affiliations
Corresponding author
Ethics declarations
Competing interests
The authors declare no conflict of interest.
Additional information
This study was previously presented as an abstract at ARVO 2009.
Rights and permissions
About this article
Cite this article
Khandhadia, S., Trump, D., Menon, G. et al. X-linked retinoschisis maculopathy treated with topical dorzolamide, and relationship to genotype. Eye 25, 922–928 (2011). https://doi.org/10.1038/eye.2011.91
Received:
Revised:
Accepted:
Published:
Issue date:
DOI: https://doi.org/10.1038/eye.2011.91
Keywords
This article is cited by
-
Cystoid macular oedema without leakage in fluorescein angiography: a literature review
Eye (2023)
-
Outcome measures in juvenile X-linked retinoschisis: A systematic review
Eye (2020)
-
Genetic analysis and clinical features of X-linked retinoschisis in Chinese patients
Scientific Reports (2017)
-
Topical dorzolamide treatment of macular cysts in the enhanced S-cone syndrome patient
Documenta Ophthalmologica (2013)